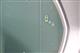

修復歴
- なし
特記事項
- タッチペン跡
- タイヤひび割れ
- 芳香剤臭い
- パンク修理剤あり
内装特記事項
- コンソール傷あり
- シフトノブすれあり
- シートしわあり
- 室内臭いあり
- ダッシュボードのり跡あり
- ピラー内張汚れあり
-
注1)
本ページに掲載された評価は、車両検査実施時の車両状態を示したものです。
検査には厳正を期しておりますが、保証したものではございませんのでその旨ご了承ください。
詳細及び現状の車両状態につきましては、店舗スタッフまでお尋ねください。 -
注2)
上記と同様の評価点・状態表を「車両検査証明書」として店舗の展示車両に搭載しております。

写真あり
写真あり 写真なし
写真なし



 サビ
サビ ヘコミ
ヘコミ 腐食
腐食 キズを伴うヘコミ
キズを伴うヘコミ フロントガラスの点キズ
フロントガラスの点キズ 色あせ・塗装はがれ
色あせ・塗装はがれ 割れ、破れ、裂け等
割れ、破れ、裂け等 補修した跡
補修した跡 交換済み
交換済み は応急タイヤの装着を示しています。
は応急タイヤの装着を示しています。




























































